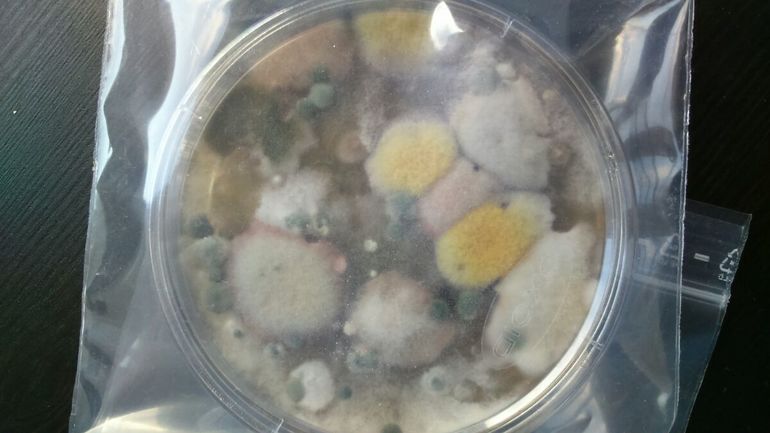
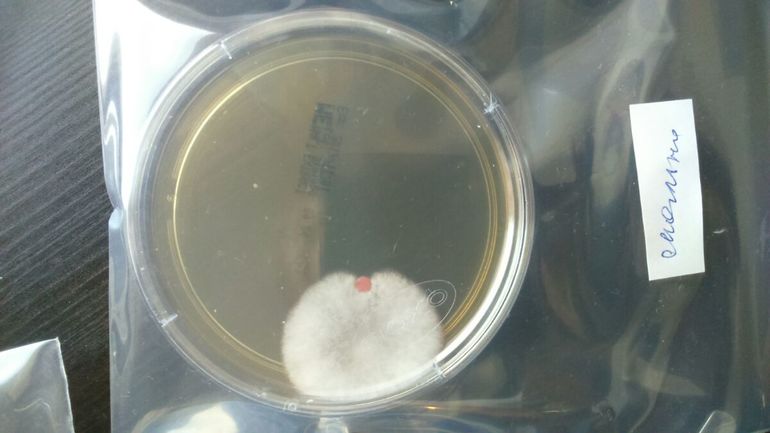
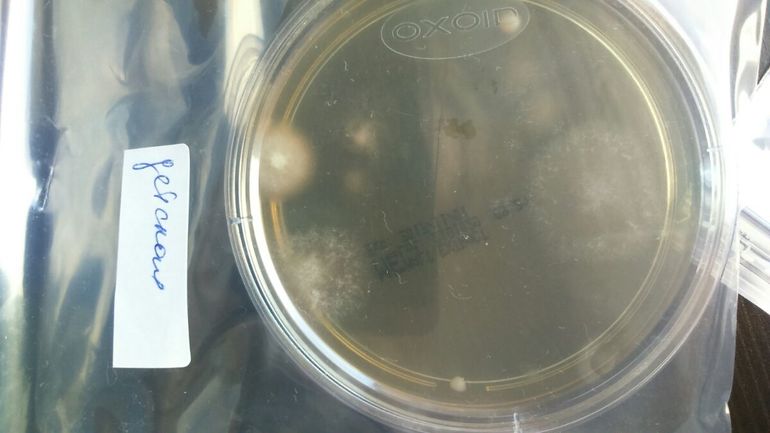

Когда то давно когда мы только переехали в Германию и не знали с местной системе проветривания у нас завелась плесень. На Украине такого не была, там квартира с вентиляцией и воздух сухой. Тут же даже вытяжки нет. Потом мы изучили информацию и боролись с плесенью спреем, проветриванием и купили Entfeuchter. Плесень больше не появлялась,только иногда на кухне на стене. Там сразу же убираем. Появился ребенок и я как то разпереживалась по этому поводу, хотя судя по информации из интернета то квартира неопасная в этом плане. Недавно я все таки решила провести исследование. Заказала на амазоне чашки петри со средой,для определение нагрузки спорами плесени в квартире. Все сделала. Надо ждать 10 дней. Сейчас день 5й результаты:
Улица
Кухня 
Wohnzimmer 
Спальня
Детская
По сравнению с улицей у нас стерильно)))) но меня немного пугает детская комната. Хотя в инструкции пишут что считать нужно только цветные колонии,белые не в счет. Самые опасные черные,серые. Посмотрим что покажет день 10й. Но улица меня ужаснула.